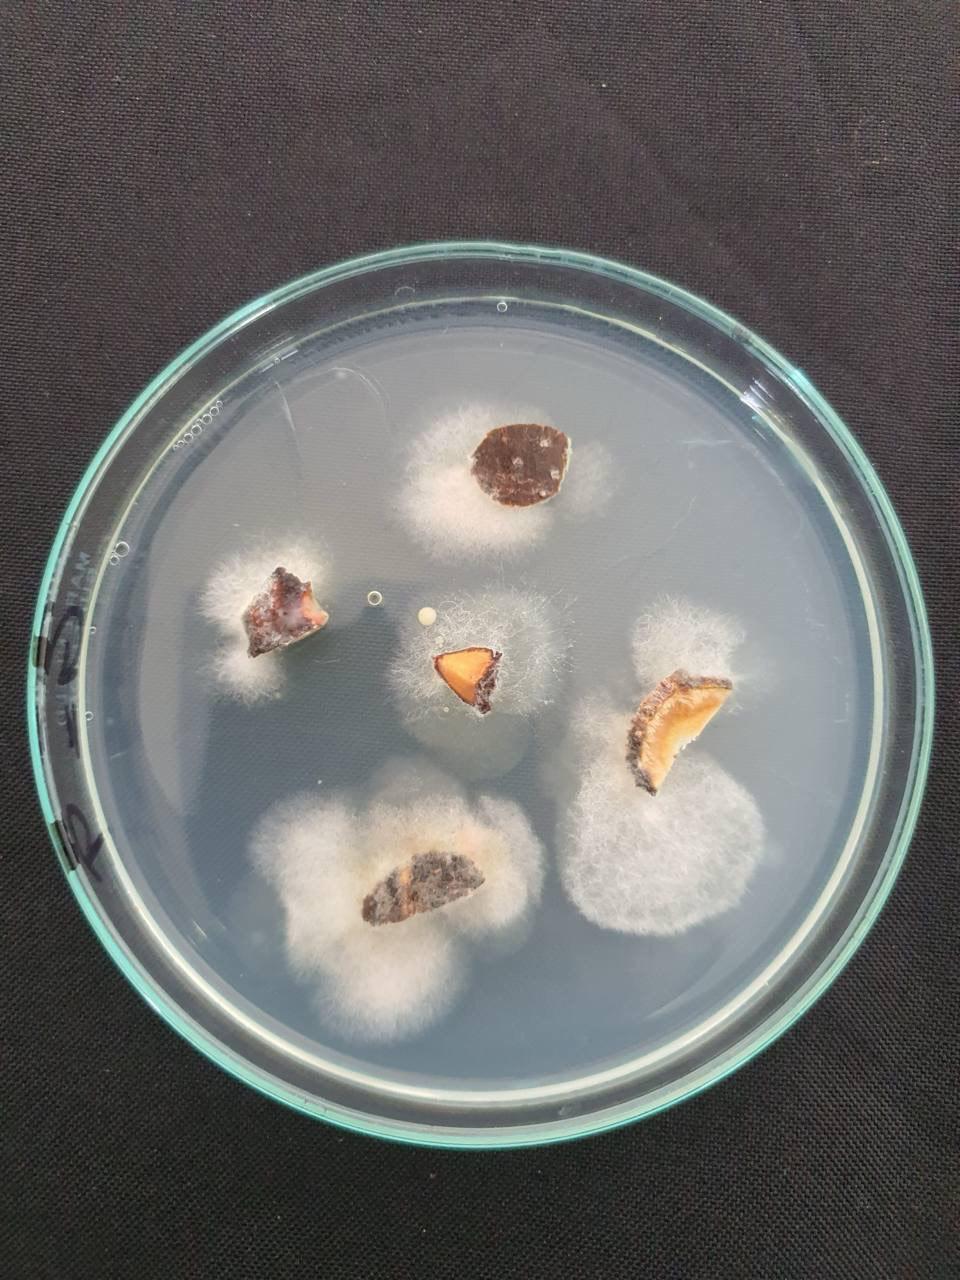

Estudios: Fitopatológicos, fertilización y de nutrición a materia vegetal, raíz y suelo.
Asesoría a plantaciones comerciales.
Tratamientos especiales (Endoterapia).
Control y combate de diferentes plagas en el arbolado.
Asesoría y mantenimiento a fraccionamientos y zonas residenciales.
Podas sanitarias, de confirmación y alto riesgo.
Mantenimiento de arbolado a Club’s de Golf y Deportivos.